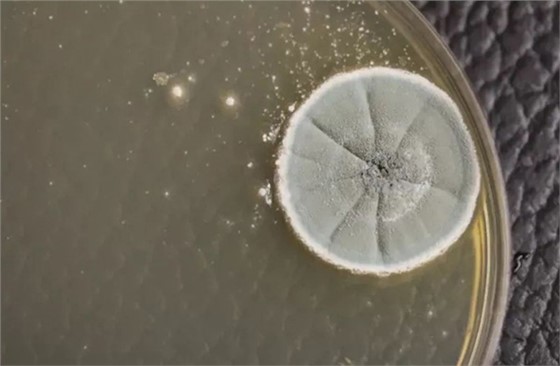
飞机客舱最脏的地方在哪里？看完触目惊心！

用过的卫生棉,吃一半的三明治残渣,使用过的避孕套,臭污不堪的尿布。。。。你相信吗?这些令人作呕的脏东东,全都会出现在飞机上同一个地方。而那个地方,不是飞机上的垃圾桶,而是座椅背后的网兜。然而,不要就此以为,网兜就是飞机上最脏的地方了,飞机上真正最脏的地方,在你想都想不到的地方,下面就和腾龙航材小编一起来看看吧。

最近,Marketplace市场调查向加拿大人们揭示了一个难以置信的飞机真面目,加拿大航班飞机上哪个地方最脏?表面看起来干净整洁的机舱里到底隐藏着多少污垢和病菌?调查的结果让人触目惊心!这次的调查,对加拿大国内18个航班飞机取样抽检,其中包括加航,西捷以及Porter航空一共三家加拿大航空公司的飞机,主要是境内航线航班。
在18个航班上,总共取了100个样品,送去圭尔夫大学的微生物实验室抽检,抽检工作由微生物学家Keith Warriner负责。

100个样品抽检的结果怎样?Keith Warriner教授对记者说,简直有点受到了惊吓,居然发现了这么细菌霉菌和病原体!他说,接近50%的样品中,都含有酵母菌,霉菌,细菌,而且含量已经达到了可致病的程度。

图:抽样的结果显示,飞机客舱中发现了惊人的致病菌和病原体量。
18个航班飞机上,几乎全部发现了酵母菌和霉菌,这两种菌是在长期没有做好清洁的情况下才可能发生,说明了飞机客舱存在长期清洁不良的情况。飞机客舱到底哪些地方最脏呢?抽检的结果会让你大吃一惊的!
飞机客舱最脏Top5:安全带

一上飞机就要系的安全带,因为直接与数不清的乘客手相接触,并且也很容易被清洁人员忽视,成了一个大量携带酵母菌和霉菌的地方。被抽检的安全带中,三分之一都发现了酵母菌和霉菌,另外还发现了较低程度的好氧菌。
飞机客舱最脏Top4:小桌板

按理说,小桌板应该是飞机客舱最干净的地方才对,毕竟这是乘客吃饭喝水的场所呀。但是抽检的结果却让人大跌眼镜!抽检人员在样品上发现了大量霉菌和溶血细菌,葡萄球菌数量也不在少数。
如果人体与大量的葡萄球菌接触,可能导致皮肤和软组织感染,例如皮肤疖肿。微生物学家Tetro建议,乘客最好是不要直接埋头在小桌板上睡觉,因为这样会让脸部直接接触桌板上的葡萄球菌和霉菌;也不要将送进嘴吃的食物直接放置在桌板上,这会极大增加你被感染的几率。
飞机客舱最脏Top3:洗手间门把手

说到洗手间的门把手脏,原因大家也能很容易想到,上厕所进出的地方脏也不奇怪。因为一定会有人上完厕所后没洗手或者是没洗干净手就出来了。。。手再与门把手接触,细菌就沾了上去,进出洗手间的人你来我往的都要拉一拉洗手间的门把手,这地方能干净吗?
抽样的结果表明,在三分之一的送检洗手间门把手上,都发现了溶血细菌和好氧细菌。溶血细菌容易导致乘客感染上链球菌性喉炎。
飞机客舱最脏Top2:椅背网兜

客舱乘客椅背上的网兜里,经常会藏着令人作呕的物品,包括文章最开始说的卫生棉,尿布等,大多是不讲卫生的乘客留下来的物品。例如小孩尿布这些东西,往往携带着粪便赃污物。抽检小组在网兜上发现了大肠杆菌E.coli,就是网兜里有粪便残留物的证据。
而网兜偏偏是功能使用最多的一个地方,有乘客在里面放零食或者饮料,也有人会将耳塞或者手机等塞在里面。却殊不知在不知不觉中接触了大肠杆菌,一不小心很可能会导致肠道感染,引起腹泻,呕吐,或者腹部痉挛。微生物学家在网兜样品里发现了第二高的好氧细菌,大肠杆菌,霉菌,以及其它大肠菌。
飞机客舱最脏Top1:座椅头垫

什么?乘客座椅上的头垫居然是最脏的地方?看到这个结果,很多小伙伴肯定不相信,但是抽检的结果却是实打实的。微生物学家也对这个结果表示震惊,但是他们确实在头垫样品中发现了最高程度的好氧菌,最好程度的溶血细菌和葡萄球菌。
这给乘客造成了很大的潜在致病风险。如果有乘客睡觉时侧头或者脸部超下接触到头垫,很可能会因此吸入溶血细菌和葡萄球菌。并且,一旦皮肤上有破损处,这些病菌很容易就会侵入到人体内,人体可能会因此感染脓疱疮或者膀胱炎。
这样令人震惊的抽检结果,反应了加拿大飞机航班的卫生情况令人着实堪忧,Marketplace调查小组找到航空公司,希望他们能给出解释或回复。
为什么飞机客舱的卫生情况这么差?
一些客服和空乘人员接受了采访,在问及为什么飞机客舱里的清洁卫生这么差时,他们大多也表示很无奈。他们说,主要原因,是因为没有足够的时间来彻底清洁客舱。每次从落地到重新起飞之间的时间短暂,大约只有15分钟的时间用来做清洁,这么短的时间,大多数情况都是只能做到表面上的干净。
并且,飞机上提供的清洁用品是有限的,因为安全因素的考虑,很多家用的消毒剂和清洁剂在飞机上不允许用的,只能要么用水冲,要么用餐巾纸擦。没有时间打扫,清洁用品又有限,你还能指望飞机客舱能有多干净?所以,以后乘坐飞机时,有必要要自己额外注意了。带上消毒湿纸巾,落座之前,仔细擦一遍飞机上的座椅,安全带,小桌板,头垫等,每次用完洗手间后,也用消毒纸巾擦干净手,做好额外的防护,确保不要被飞机上隐藏的污垢和病菌击中,保护自己和家人健康是第一要务。
深圳腾龙航天器材有限公司,专做航空器材的清洁和养护提供专业解决方案,提供飞机维护整洁服务,旗下产品广泛应用于各类场所,针对常见污染物及各种引起异味的病菌起到生物除菌作用,且长效持久、绿色无毒、无需频繁操作,大大改善工作和生活环境,提高生活质量。



